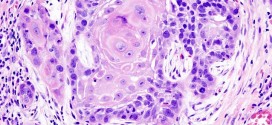

Las afecciones prostáticas. Ver en prostatitis.
Leer MásEnfermedades
LINFOMA MALIGNO DEL BAZO
El linfoma maligno del bazo. Tumor maligno en general y especialmente el formado por células epiteliales, a saber. Los canceres se dividen en dos grandes categorías de carcinoma y sarcoma u otros. La característica básica de la malignidad es una anormalidad de las células, transmitida a las células hijas, que se manifiesta por la reducción del control del crecimiento y …
Leer MásESTRÍA
El estría. Línea cutánea blanquecina, plana, deprimida o sobre elevada formada por tejido epidérmico ligeramente atrofiado. Se produce por alteraciones endocrinas, como el síndrome de Cushing, fiebre tifoidea, ascitis o por una distensión de la piel, como las que se producen durante el embarazo. Pero también pueden afectar a las jovencitas en el periodo de la pubertad o a mujeres …
Leer MásDERMATOSIS PARANEOPLÁSICA
La dermatosis paraneoplásica. Tumor maligno ó manchas malignas en general y especialmente el formado por células epiteliales o pigmentarias. Durante los primeros años de vida de una persona, las células normales se dividen más rápidamente para permitir el crecimiento. El cuerpo está compuesto por billones de células vivas. Las células normales del cuerpo crecen, se dividen formando nuevas células y …
Leer MásCARCINOMA PAPILAR RENAL
El carcinoma papilar renal. Tumor maligno en general y especialmente el formado por células epiteliales, se presenta en el parénquima del riñón, es la forma más usual de cáncer y se origina en la proliferación de células epiteliales de los túbulos renales. Los riñones son dos órganos de color marrón rojizo con forma de poroto, cada uno de los cuales …
Leer MásCARCINOMA NASOFARÍNGEO
El carcinoma nasofaríngeo. La nasofaringe es la porción superior de la faringe (garganta) situada detrás de la nariz. La faringe es un tubo hueco de unos 12 centímetros de longitud que comienza detrás de la nariz y termina en la parte superior de la tráquea y el esófago (el conducto que va de la garganta al estómago). Por la faringe …
Leer MásCARCINOMA LOBULAR INVASIVO DE MAMA
El carcinoma lobular invasivo de mama. Los senos de una mujer están formados por glándulas mamarias (lobulillos) que producen leche, conductos (pequeños tubos que llevan la leche de los lobulillos al pezón), tejido adiposo y conectivo, vasos sanguíneos y vasos linfáticos. La mama está dividida en unas 20 partes (lóbulos), que a su vez se dividen en partes más pequeñas …
Leer MásCARCINOMA ESPINOCELULAR DEL OIDO
El carcinoma espinocelular del oído. Durante los primeros años de vida de una persona, las células normales se dividen más rápidamente para permitir el crecimiento. El cuerpo está compuesto por billones de células vivas. Las células normales del cuerpo crecen, se dividen formando nuevas células y mueren de manera ordenada. Una vez que se llega a la edad adulta, la …
Leer MásCARCINOMA DE CÉLULA DE SQUAMOUS DE LA AMÍGDALA
El carcinoma de célula de squamous de la amígdala. El carcinoma de célula de Squamous de la amígdala es el cáncer lo más comúnmente posible diagnosticado de todos los cánceres principales y de cuello. Casi todos los cánceres orales comienzan en las células planas (células squamous), esa cubierta de las superficies de la boca, de la lengüeta y de los …
Leer MásCARCINOMA DE CÉLULAS CLARAS (de ovario)
El carcinoma de células claras (de ovario). Ver cáncer de ovario.
Leer MásCÁNCER SUBGLÓTICO PRIMARIO
El cáncer subglótico primario. La región subglótica empieza cerca de 1 centímetro abajo de las cuerdas vocales verdaderas y se extiende hasta el borde inferior del cartílago cricoides o el primer anillo traqueal. El espacio supraglótico está formado por la epiglotis, bandas ventriculares y ventrículos de Morgagni hasta un poco por encima de cuerdas vocales. El área supraglótica es rica …
Leer MásAMIGDALITIS HIPERPLASICA CRONICA UNILATERAL
La amigdalitis hiperplásica crónica unilateral. Durante los primeros años de vida de una persona, las células normales se dividen más rápidamente para permitir el crecimiento. El cuerpo está compuesto por billones de células vivas. Las células normales del cuerpo crecen, se dividen formando nuevas células y mueren de manera ordenada. Una vez que se llega a la edad adulta, la …
Leer MásATEROSCLEROSIS DE LOS MIEMBROS INFERIORES
La aterosclerosis de los miembros inferiores. Por: Salvador Gregori Resumiendo: Dureza y engrosamiento anormales de las paredes arteriales, resultado de inflamaciones, especialmente de la túnica íntima con tendencia a la obliteración del vaso. Parece que la tendencia a desarrollar aterosclerosis en algunos grupos familiares puede ser debida a factores genéticos hereditarios que influyen en los factores de riesgo (hiperlipemia, HTA, …
Leer MásAMNESIA ANTERÓGRADA
La amnesia anterógrada. Los nuevos eventos no son transferidos a la memoria a largo plazo, así que el que la sufre no será capaz de recordar nada que haya ocurrido después del inicio de este tipo de amnesia por más que un pequeño momento. Se la conoce también como Amnesia de Fijación. Las causas de la amnesia son orgánicas o …
Leer MásAGNOSIA
La agnosia. Alteración de las capacidades perceptivas y de reconocimiento de los objetos sin que exista un déficit sensorial. Se distinguen diferentes tipos de agnosias según el sentido afectado: agnosia auditiva, visual, olfativa, táctil o gustativa, etc. La agnosia produce una pérdida en la capacidad de reconocer sonidos (agnosia auditiva), objetos o personas (agnosia visual), sabores (agnosia gustativa) u olores …
Leer MásAFASIA DE BROCA
La afasia de broca. Afasia expresiva o motora por lesiones que exceden habitualmente el área del mismo nombre y que se caracteriza por una imposibilidad de expresar el pensamiento mediante palabras, gestos o escritura. Afasia de Broca (afasia motora mayor) Este término designa un síndrome complejo, en el cual predomina la insuficiencia de los aspectos motores del lenguaje y de …
Leer MásLINFOMA GÁSTRICO
El linfoma gástrico. El estómago es un órgano hueco en forma de letra ‘J’ o de gaita que se sitúa en la zona más alta del abdomen y forma parte del aparato digestivo. Recibe el alimento que ingerimos por la boca a través del esófago. Cuando penetra la comida en su interior, los músculos del estómago comienzan a contraerse rítmicamente …
Leer MásHIDROPESIA
Hidropesía, acumulación de líquido seroso trasudado en una cavidad o en el tejido celular. Edema o retención de líquido en los tejidos. Resumiendo: El origen de la hidropesia se encuentra en los estados patológicos que dificultan la libre circulación de la sangre en el interior de los vasos, provocando la estasis de la misma y el aumento de la trasudación …
Leer MásECZEMA MARGINADO
El eczema marginado. Eczema cutáneo provocado por la infestación del hongo Epidermophyton inguinale. La afección se caracteriza por la aparición de eritemas (manchas rojas de bordes eccematosos) acompañados de picor localizados preferentemente en la cara interna de los muslos, las ingles y las axilas. Pues bien una vez diagnosticado cual es la enfermedad o nombre de dicha patología, lo primero …
Leer MásCOLESTEATOMA
El colesteatoma. Tumor, quiste, etc; normalmente es benigno constituido por una masa circunscrita de tejido adiposo ó constituidos por la proliferación de tejido celular subcutáneo. Es un tumor, quiste, absceso, etc; benigno compuesto de tejido adiposo, a veces encapsulado que se manifiestan como masas redondas bien definidas con una pared visible y homogénea. Tiene un crecimiento lento de masa grasa …
Leer Más Binipatia e higienismo Medicina natural alternativa, plantas medicinales y remedios caseros naturales
Binipatia e higienismo Medicina natural alternativa, plantas medicinales y remedios caseros naturales